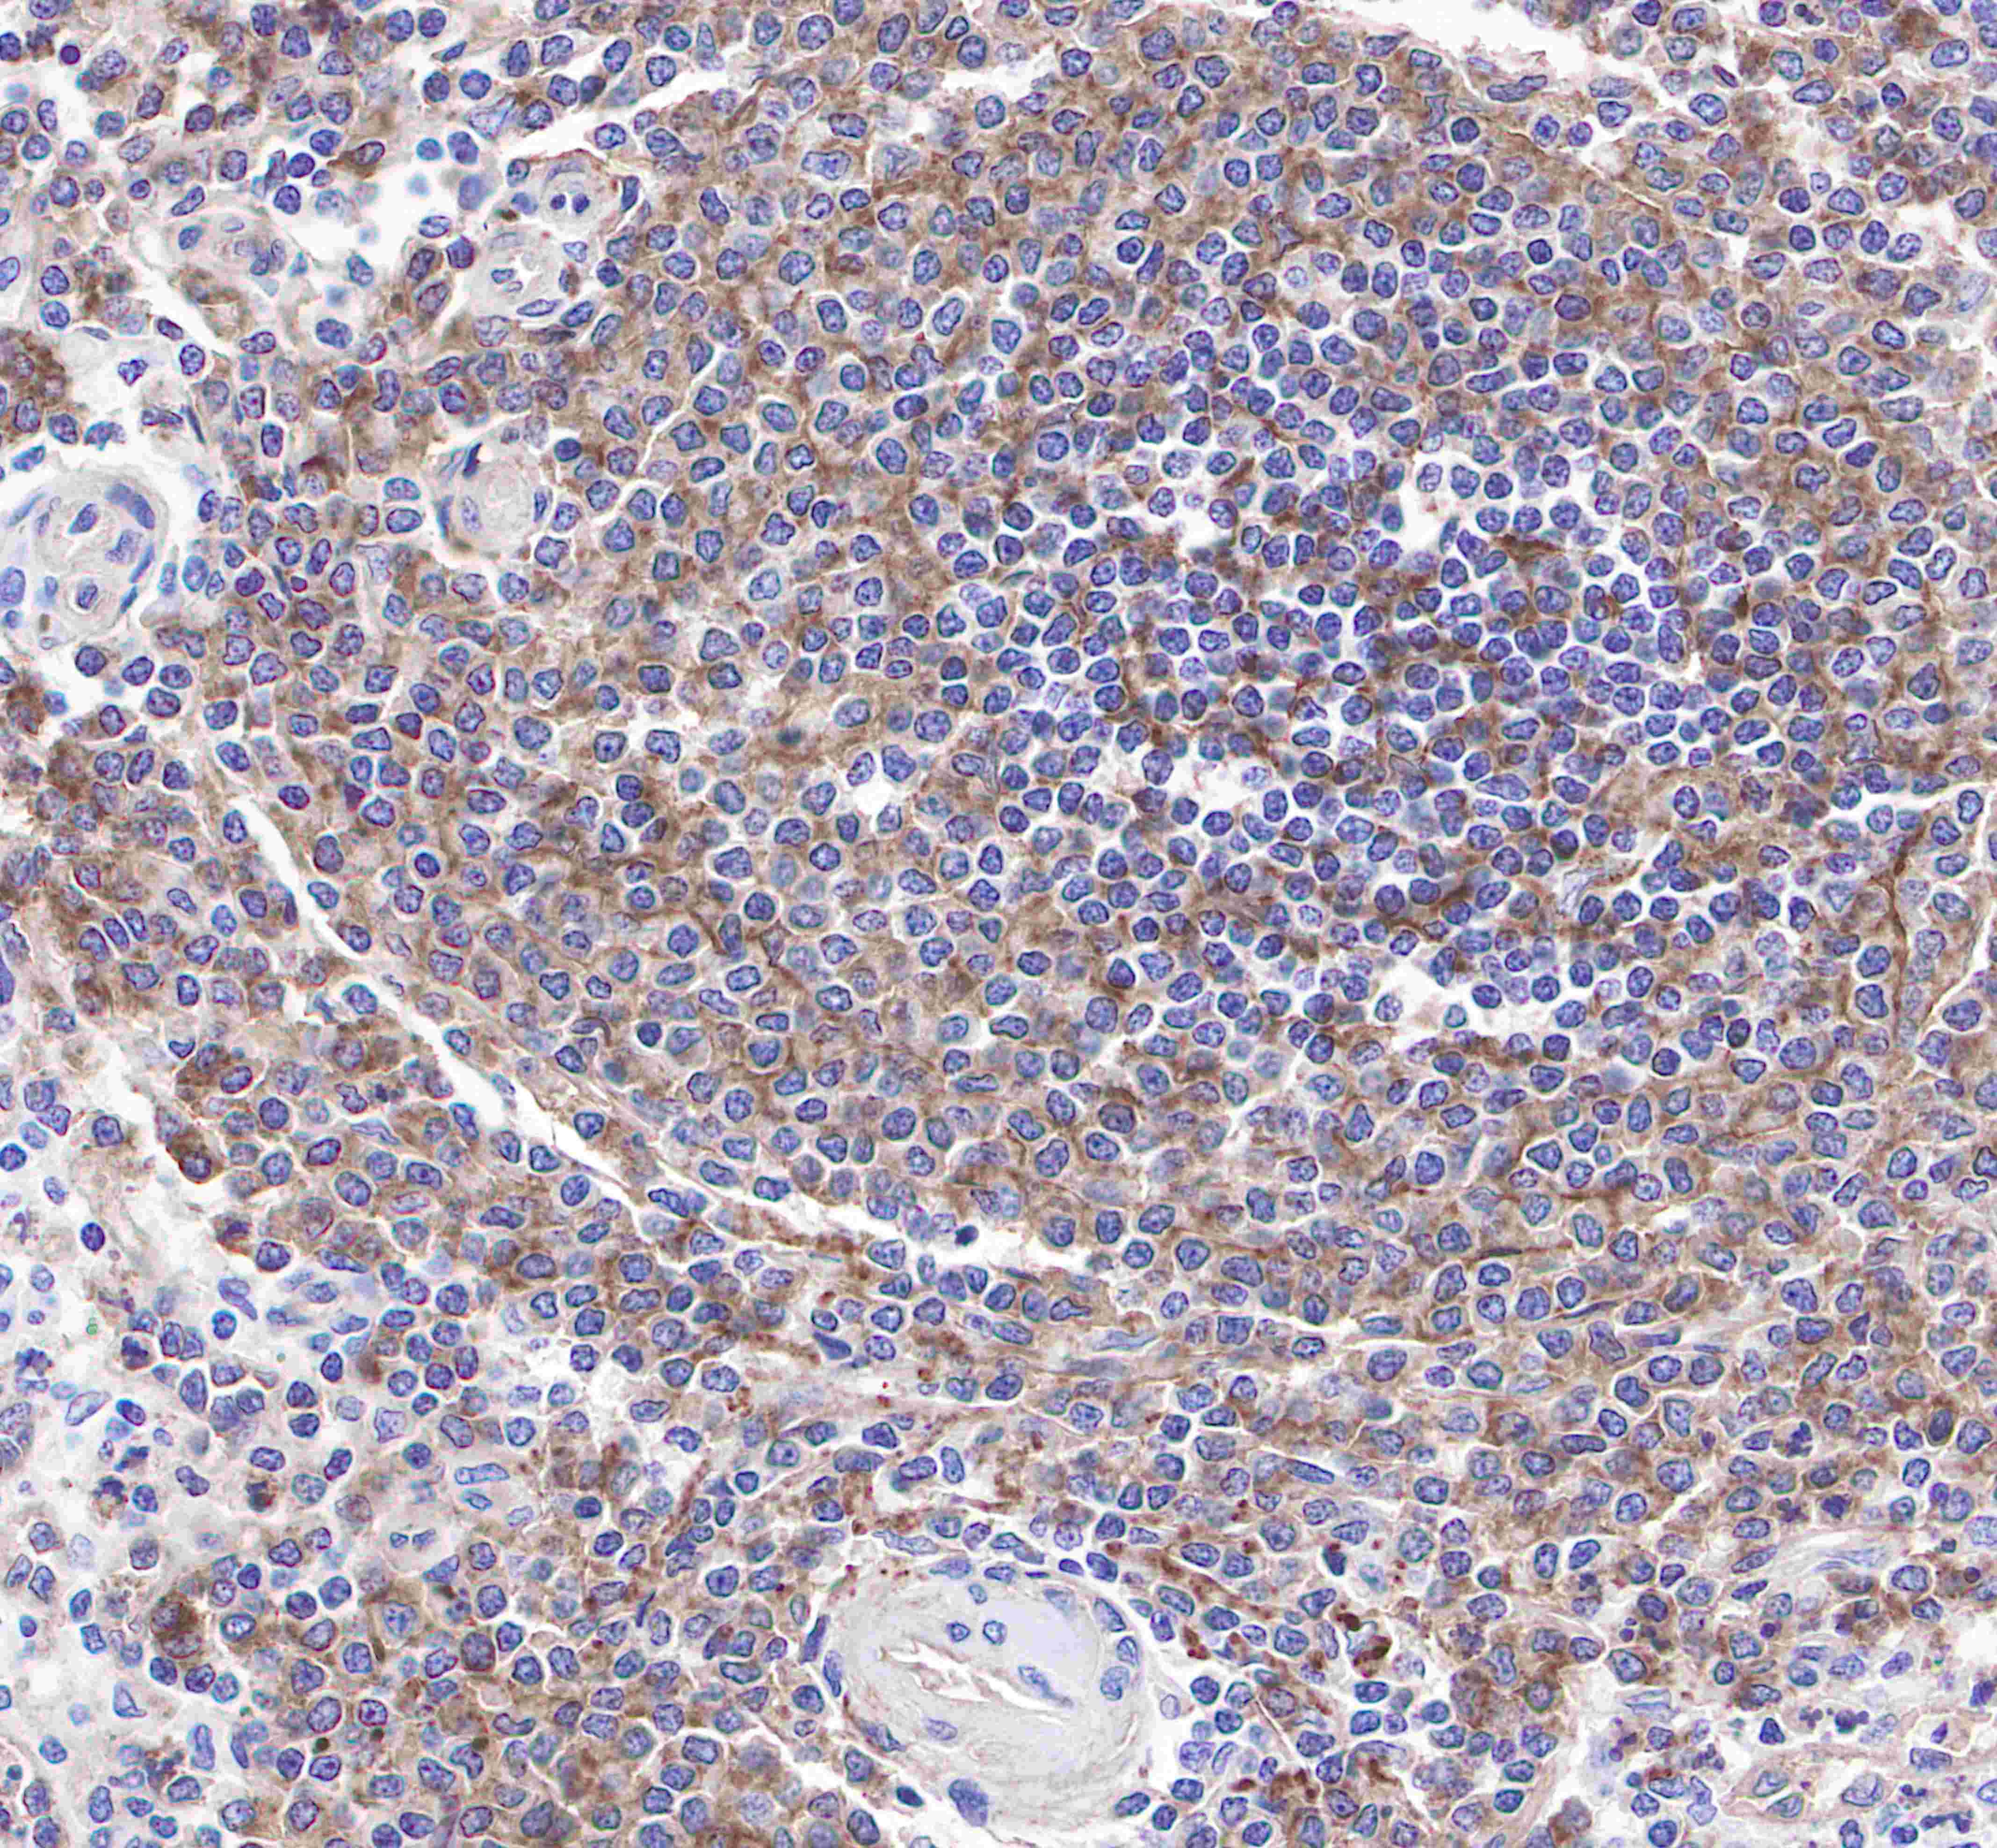

IHC shows positive staining in paraffin-embedded human tonsil. Anti-CD21 antibody was used at 1/1000 dilution, followed by a Goat Anti-Rabbit IgG H&L (HRP) ready to use. Counterstained with hematoxylin. Heat mediated antigen retrieval with Tris/EDTA buffer pH9.0 was performed before commencing with IHC staining protocol.
Product Details
Product Details
Product Specification
| Host | Rabbit |
| Antigen | CD21 |
| Synonyms | Complement receptor type 2, Cr2, Complement C3d receptor, Epstein-Barr virus receptor (EBV receptor) |
| Immunogen | Synthetic Peptide |
| Accession | P20023 |
| Clone Number | SDT-007-36 |
| Antibody Type | Rabbit mAb |
| Isotype | IgG |
| Application | IHC-P |
| Reactivity | Hu, Ms |
| Purification | Protein A |
| Research Area | Immunology |
| Concentration | 0.08 mg/ml |
| Molecular Weight | 113kDa |
| Conjugation | Unconjugated |
| Physical Appearance | Liquid |
| Storage Buffer | PBS, 40% Glycerol, 0.05%BSA, 0.03% Proclin 300 |
| Stability & Storage | 12 months from date of receipt / reconstitution, -20 °C as supplied |
Dilution
| application | dilution | species |
| IHC-P | 1:1000 |
Background
CD21 is involved in the complement system. It binds to iC3b (inactive derivative of C3b), C3dg, or C3d.B cells express CD21 receptors on their surfaces, allowing the complement system to play a role in B-cell activation and maturation. CD21 interacts with CD19 and on mature B cells forms a complex with CD81 (TAPA-1). The CD21-CD19-CD81 complex is often called the B cell co-receptor complex, because CD21 binds to opsonized antigens through attached C3d (or iC3b or C3dg) when the B-cell receptor binds antigen. This results in the B cell having greatly enhanced response to the antigen. Epstein-Barr virus (EBV) can bind CD21, enabling EBV to enter and infect B cells.
Picture
Picture
Immunohistochemistry

IHC shows positive staining in paraffin-embedded human spleen. Anti-CD21 antibody was used at 1/1000 dilution, followed by a Goat Anti-Rabbit IgG H&L (HRP) ready to use. Counterstained with hematoxylin.
Heat mediated antigen retrieval with Tris/EDTA buffer pH9.0 was performed before commencing with IHC staining protocol.

IHC shows positive staining in paraffin-embedded mouse spleen. Anti-CD21 antibody was used at 1/1000 dilution, followed by a Goat Anti-Rabbit IgG H&L (HRP) ready to use. Counterstained with hematoxylin.
Heat mediated antigen retrieval with Tris/EDTA buffer pH9.0 was performed before commencing with IHC staining protocol.






